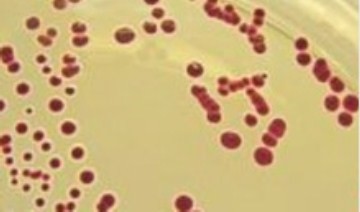
硅酸盐细菌培养基(上海)

如果一个菌落是由一个细菌繁殖面来,则为纯培养。每种菌在一定条件下的菌落特征是一定的,在相同条件下菌落特征是改变,常标志着细菌生理性状发生了变异,如光滑型变成了

上海隔水式电热培养箱和二氧化碳细菌培养箱特
341x340 - 12KB - JPEG

空气细菌采样器有哪些特点_空气细菌采样器有
266x267 - 33KB - JPEG
硅酸盐细菌培养基(上海)
360x212 - 14KB - JPEG

上海细菌恒温培养箱高低温恒温振荡培养箱特征
260x260 - 6KB - JPEG

伟询仿岩石橱柜门板种类与特点_上海伟询橱柜
650x427 - 51KB - JPEG

WGZ-2XJ细菌浊度计 上海昕瑞
500x380 - 139KB - JPEG

细菌性鱼病特征及防治(上).pdf 全文免费在线阅
800x1076 - 351KB - PNG

草鱼养殖池塘蓝藻暴发时水体细菌群落特征分析
794x1123 - 61KB - PNG

换季保养 如何让空调不再成为细菌温床_【上海
385x385 - 17KB - JPEG

SPX-150B-Z 上海博迅生化培养箱 细菌、霉菌
300x276 - 7KB - JPEG

空气细菌采样器有哪些特点_上海材晨精密仪器
240x180 - 5KB - JPEG

2015年高考真题--生物(上海卷) 含答案.doc
794x1123 - 64KB - PNG

上海培因生化培养箱250L细菌培养箱
600x800 - 50KB - JPEG

【千金妙方】老年白癜风患者的症状特点 上海
557x349 - 37KB - JPEG

2015年上海卷(生物)word高清版.docx免费全文
993x1404 - 104KB - PNG